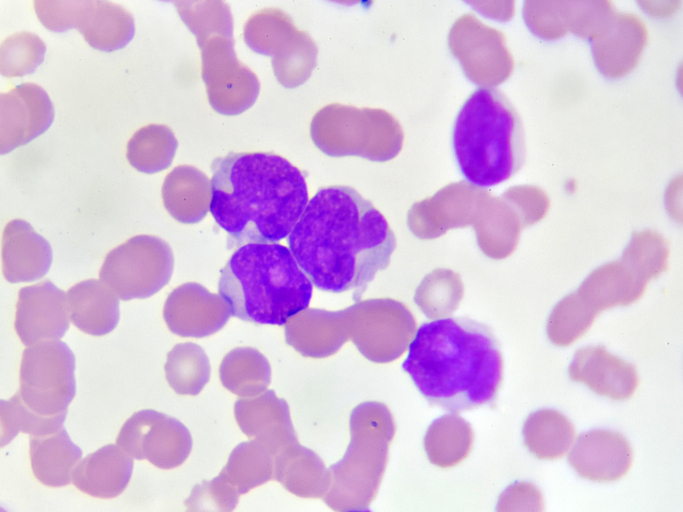
AML cell image

A Study to Compare Standard Chemotherapy to Therapy With CPX-351 and/or Gilteritinib for Patients With Newly Diagnosed AML With or Without FLT3 Mutations
The overall goal of this study is to compare the effects, good and/or bad, of CPX-351 with daunorubicin and cytarabine on people with newly diagnosed acute myeloid leukemia (AML) to find out which is better, and to find out what effects, good and/or bad, the drug gilteritinib has when given wi...
About
Protocol Description
A Phase 3 Randomized Trial for Patients With De Novo AML Comparing Standard Therapy Including Gemtuzumab Ozogamicin GO To CPX-351 With GO, and the Addition of The FLT3 Inhibitor Gilteritinib for Patients With FLT3 Mutations
The overall goal of this study is to compare the effects, good and/or bad, of CPX-351 with daunorubicin and cytarabine on people with newly diagnosed acute myeloid leukemia (AML) to find out which is better, and to find out what effects, good and/or bad, the drug gilteritinib has when given with chemotherapy to children and young adults with newly diagnosed AML and the FLT3/ITD mutation or non-ITD FLT3 activating mutations.
COG# AAML1831
Eligibility Criteria
Inclusion Criteria
- Patient must be newly diagnosed with de novo AML according to the 2016 WHO classification with or without extramedullary disease.
- Less than 22 years of age at diagnosis
- All patients must be enrolled on APEC14B1 and consented to Eligibility Screening (Part A) prior to enrollment and treatment on AAML1831.
Exclusion Criteria
Patients with the following constitutional conditions are not eligible:
- Patients with myeloid neoplasms with germline predisposition
- Fanconi anemia
- Shwachman Diamond syndrome
- Patients with constitutional trisomy 21 or with constitutional mosaicism of trisomy 21
- Any other known bone marrow failure syndrome
Patients with any of the following oncologic diagnoses are not eligible:
- Any concurrent malignancy
- Juvenile myelomonocytic leukemia (JMML)
- Philadelphia chromosome positive AML
- Mixed phenotype acute leukemia
- Acute promyelocytic leukemia
- Acute myeloid leukemia arising from myelodysplasia
- Therapy-related myeloid neoplasms
Prior Therapy
Administration of prior anti-cancer therapy except as outlined below:
- Hydroxyurea
- All-trans retinoic acid (ATRA)
- Corticosteroids (any route)
- Intrathecal therapy given at
Primary Investigator

Dr. Glenn Edwards is the section chief of Pediatric Hematology/Oncology, as well as the Children's Oncology Group's principal investigator for Carilion Clinic, and has over 30 years of clinical experience. He is board certified by the American Board of Pediatrics in Pediatrics and Pediatric Hematology/Oncology. He completed his fellowship at Walter Reed Army Medical Center and completed his internship and residency at Tripler Army Medical Center.
Contact Information
Wendy McCarty, CCRP
Clinical Research Coordinator II